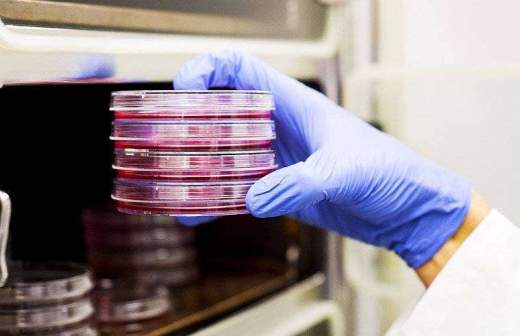

В США созданы инсулиновые таблетки

Американские биотехнологи создали инсулиновые таблетки, способные доставить инсулин в организм диабетика, сохранив лекарство в полном объеме при движении через желудок.
Для стабилизации уровня сахара в крови людям, страдающим от диабета, приходится принимать по несколько инъекций инсулина в день, так как желудочный сок и ферменты разлагают молекулы препарата еще до их всасывания стенками кишечника. При этом препарат является достаточно опасным гормоном и его передозировка может нанести серьезный ущерб здоровью.
Создать новую технологию удалось ученым из Гарварда и университета Калифорнии в Санта-Барбаре, результаты исследований опубликованы в журнале PNAS.
«Мы создали своеобразный «швейцарский нож», в который встроены все необходимые инструменты для защиты инсулина от тех угроз, которые он встречает на своем пути», — цитирует Самира Митраготри из Гарварда агентство «РИА Новости».
Медики создали стойкую к действию желудочной кислоты оболочку и субстанцию, которую химики называют «ионной жидкостью» — смесь солей без единой молекулы воды, которая при этом ведет себя как жидкость. Смесь защитит инсулин от ферментов при движении через кишечник, а также позволит препарату действовать около 12 часов и храниться около двух месяцев в аптечке даже при комнатной температуре.
В дальнейшем таблетки будут проходить клинические испытания и должны появиться в аптеках уже в ближайшие несколько лет.